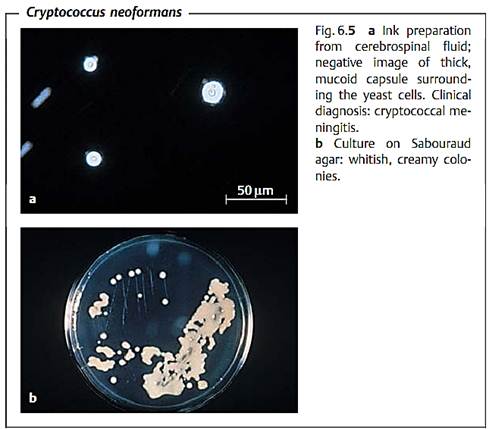

Opportunistic Mycoses (OM)
Opportunistic mycoses (OM) that affect skin and mucosa as well as internal organs are caused by both yeast and molds. A precondition for development of such infections is a pronounced weakness in the host's immune defenses. Candidiasis is an endogenous infection. Other OMs are exogenous infections caused by fungi that naturally inhabit the soil or plants. These environmental fungi usually invade via the respiratory tract. The most important are aspergillosis, cryptococcosis, and the mucormycoses. Besides Candida and other yeasts, phaeohyphomycetes and hyalohyphomycetes, which are only very mildly pathogenic, can also cause systemic infections. All OMs have a primary infection focus, usually in the upper or lower respiratory tract. From this focus, the pathogens can disseminate hematogenously and/or lymphogenously to infect additional organs. Infection foci should be removed surgically if feasible. Antimycotic agents are used in chemotherapy. In infected immunocompromised patients, the prognosis is usually poor.
Candida (Soor)
At least 70 % of all human Candida infections are caused by C. albicans, the rest by C. parapsilosis, C. tropicalis, C. guillermondii, C. kruzei, and a few other rare Candida species.

Morphology and culture. Gram staining of primary preparations reveals C. albicans to be a Gram-positive, budding, oval yeast with a diameter of approximately 5 µm. Gram-positive pseudohyphae are observed frequently and septate mycelia occasionally (Fig. 6.2).
C. albicans can be grown on the usual culture mediums. After 48 hours of incubation on agar mediums, round, whitish, somewhat rough-surfaced colonies form. They are differentiated from other yeasts based on morphological and biochemical characteristics.
Pathogenesis and clinical pictures. Candida is a normal inhabitant of human and animal mucosa (commensal). Candida infections must therefore be considered endogenous. Candodoses usually develop in persons whose immunity is compromised, most frequently in the presence of disturbed cellular immunity. The mucosa are affected most often, less frequently the outer skin and inner organs (deep candidiasis). In oral cavity infections, a white, stubbornly adherent coating is seen on the cheek mucosa and tongue. Pathomorphologically similar to oral soor is vulvovaginitis. Diabetes, pregnancy, progesterone therapy, and intensive antibiotic treatment that eliminate the normal bacterial flora are among the predisposing factors. Skin is mainly infected on the moist, warm parts of the body. Candida can spread to cause secondary infections of the lungs, kidneys, and other organs. Candidial endocarditis and endophthalmitis are observed in drug addicts. Chronic mucocutaneous candidiasis is observed as a sequel to damage of the cellular immune system (Fig. 6.3).

Diagnosis. This involves microscopic examination of preparations of different materials, both native and Gram-stained. Candida grows on many standard nutrient mediums, particularly well on Sabouraud agar. Typical yeast colonies are identified under the microscope and based on specific metabolic evidence.
Detection of Candida-specific antigens in serum (e.g., free mannan) is possible using an agglutination reaction with latex particles to which monoclonal antibodies are bound. Various methods are used to identify antibodies in deep candidiasis (agglutination, gel precipitation, enzymatic immunoassays, immunoelectrophoresis).
Therapy. Nystatin and azoles can be used in topical therapy. In cases of deep candidiasis, amphotericin B is still the agent of choice, often administered together with 5-fluorocytosine. Echinocandins (e.g., caspofungin) can be used in severe oropharyngeal and esophageal candidiasis.
Epidemiology and prevention. Candida infections are, with the exception of candidiasis in newborn children, endogenous infections.
Aspergillus (Aspergillosis)
Aspergilloses are most frequently caused by Aspergillus fumigatus and A.flavus. A. niger, A. nidulans, and A. terreus are found less often. Aspergilli are ubiquitous in nature. They are found in large numbers on rotting plants.
Morphology and culture. Aspergillus is recognized in tissue preparations, exudates and sputum by the filamentous, septate hyphae, which are approximately 3-4 µm wide with Y-shaped branching (Fig. 6.4).

Aspergillus grows rapidly, in mycelial form, on many of the mediums commonly used in clinical microbiology. Sabouraud agar is suitable for selective culturing.
Pathogenesis and clinical pictures. The main portal of entry for this pathogen is the bronchial system, but the organism can also invade the body through injuries in the skin or mucosa. The following localizations are known for aspergilloses:
-Aspergillosis of the respiratory tract. An aspergilloma is a circumscribed “fungus ball” that usually grows in a certain space (e.g., a cavern). Another pulmonary aspergillosis is a chronic, necrotizing pneumonia. Acute, invasive pulmonary aspergillosis is seen in patients suffering from neutropenia or AIDS or following organ transplants and has a poor prognosis. Another aspergillosis of the respiratory tract is tracheobronchitis. Of all fungi, aspergilli are most frequently responsible for various forms of sinusitis. In persons with atopic allergies, asthma may be caused by an allergic aspergillus alveolitis.
-Other aspergilloses. Endophthalmitis can develop two to three weeks after surgery or an eye injury and the usual outcome is loss of the eye. Cerebral aspergillosis develops after hematogenous dissemination. Less often, Aspergillus spp. causes endocarditis, myocarditis, and osteomyelitis.
Diagnosis. Since Aspergillus is a frequent contaminant of diagnostic materials, diagnosis based on direct pathogen detection is difficult. Finding the typically branched hyphae in the primary preparation and repeated culture growth of Aspergillus make the diagnosis probable. If the branched hyphae are found in tissue biopsies stained with methenamine silver stain, the diagnosis can be considered confirmed.
Using latex particles coated with monoclonal antibodies, Aspergillus-spe- cific antigen (Aspergillus galactomannan) can be detected in blood serum in an agglutination reaction. Antibodies in systemic aspergilloses are best detected by immunodiffusion and ELISA. PCR-based methods detect Aspergillus-DNA.
Therapy. High-dose amphotericin B, administered in time, is the agent of choice. Azoles can also be used. The echinocandin caspofungin has been approved in the treatment of refractory aspergillosis as salvage therapy. Surgical removal of local infection foci (e.g., aspergilloma) is appropriate.
Cryptococcus neoformans (Cryptococcosis)
Morphology and culture. C. neoformans is encapsulated yeast. The individual cell has a diameter of 3-5 µm and is surrounded by a polysaccharide capsule several micrometers wide (Fig. 6.5a).
C. neoformans can be cultured on Sabouraud agar at 30-35 °C with an incubation period of three to four days (See Fig. 6.5b).
Pathogenesis and clinical picture. The normal habitat of this pathogen is soil rich in organic substances. The fungus is very frequently found in bird droppings. The portal of entry in humans is the respiratory tract. The organisms are inhaled and enter the lungs, resulting in a pulmonary cryptococcosis that usually runs an inapparent clinical course. From the primary pulmonary foci, the pathogens spread hematogenously to other organs, above all into the central nervous system (CNS), for which compartment C. neoformans shows a pronounced affinity. A dangerous meningoencephalitis is the result. Good preconditions for dissemination from the lung foci are provided especially by primary diseases that weaken the immune defenses. Malignancies and steroid therapy are other frequent predisposing factors. AIDS patients also frequently develop cryptococcoses.
Diagnosis. This is particularly important in meningitis. The pathogens can be detected in cerebrospinal fluid sediment using phase contrast microscopy. An ink preparation results in a negative image of the capsule (see Fig. 6.5a). Culturing is most successful on Sabouraud agar. C. neoformans can be differentiated from other yeasts and identified based on special metabolic properties (e.g., breakdown of urea). A latex agglutination test is available for detection of capsule polysaccharide in cerebrospinal fluid and serum (anticapsular antibodies coupled to latex particles). Identification of antibodies to the capsular polysaccharide is achieved by means of an agglutination test or an enzymatic immunosorbence test.
Therapy. Amphotericin B is the agent of choice in CNS cryptococcosis, often used in combination with 5-fluorocytosine.
Epidemiology and prevention. No precise figures are available on the frequency of pulmonary cryptococcosis. The incidence of the attendant meningoencephalitis is one case per million inhabitants per year. There are no specific prophylactic measures.
Mucor, Absidia, Rhizopus (Mucormycoses)
Mucormycoses are caused mainly by various species in the genera Mucor, Absidia, and Rhizopus. More rarely, this type of opportunistic mycosis is caused by species in the genera Cunninghamella, Rhizomucor, and others. All of these fungal genera are in the order Mucorales and occur ubiquitously. They are found especially often on disintegrating organic plant materials.
Morphology and culture. Mucorales are molds that produce broad, nonseptate hyphae with thick walls that branch off nearly at right angles (Fig. 6.6). Mucorales are readily cultured. They grow on all standard mediums, forming high, whitish-gray to brown, “fuzzy” aerial mycelium.
Culturing is best done on Sabouraud agar.
Pathogenesis and clinical pictures. Mucorales are typical opportunists that only cause infections in patients with immune deficiencies or metabolic dis-

orders (diabetes). The pathogens penetrate into the target organic system with dust. They show a high affinity to vascular structures, in which they reproduce, potentially resulting in thrombosis and infarction. The infections are classified as follows according to their manifestations:
-Rhinocerebral mucormycosis spreads from the nose or sinuses and may affect the brain. Most often observed as a sequel to diabetic acidosis.
-Pulmonary mucormycosis, with septic pulmonary infarctions. Occurs most frequently in neutropenic malignancy patients under remission therapy.
-Gastrointestinal mucormycosis (vary rare), seen in undernourished children and accompanied by infarctions of the gastrointestinal tract.
-Cutaneous mucormycosis, manifests as a sequel to skin injuries, especially burns.
-Disseminated mucormycosis, as a sequel to any of these forms, especially pulmonary mucormycoses.
Diagnosis. Confirmation of diagnosis is based on detection of tissue infiltration by morphologically typical fungal hyphae. Culturing can be attempted on Sabouraud agar. Identification concerns solely the morphological characteristics of the fructification organs. There is no method of antibody-based diagnosis.
Therapy. Amphotericin B is the antimycotic agent of choice. Surgical measures as required. Control of the primary disease.
Phaeohyphomycetes, Hyalohyphomycetes, Opportunistic Yeasts, Penicillium marneffei
The list of clinically relevant fungi previously not categorized as classic opportunists has lengthened appreciably in recent years. These organisms are now being found in pathogenic roles in patients with malignancies, in AIDS patients, in patients undergoing cytostatic and immunosuppressive therapies, massive corticosteroid therapy, or long-term treatment with broad- spectrum antibiotics. The terms phaeohyphomycetes, hyalohyphomycetes, and opportunistic yeasts have been created with the aim of simplifying the nomenclature.
Phaeohyphomycoses. These are subcutaneous and paranasal sinus infections caused by “dematious” molds or “black fungi.” To date, numerous genera and species have been described as pathogenic agents. Common to all is the formation of hyphae, which appear as a brownish black color due to integration of melanin in the hyphal walls. Examples of the genera include Curvularia, Bipolaris, Exserohilum, Wangiella, Dactylaria, Ramichloridium, Chaetomium, and Alternaria. The natural habitat of these fungi is the soil. They occur worldwide. Phaeohyphomycetes invade the body through injuries in the skin or inhalation of spores. Starting from primary foci (see above), the pathogens can disseminate hematogenously to affect other organs including the CNS. The clinical pictures of such infections most closely resemble the mucormycoses and aspergillosis. If feasible, surgical removal of infected tissues and administration of antimycotic agents is indicated. The prognosis is poor.
Hyalohyphomycoses. This collective term is used for mycoses caused by hyaline (melanin-free) molds. Examples of some of the genera are Fusarium, Scopulariopsis, Paecilomyces, Trichoderma, Acremonium, and Scedosporium. These fungi are also found all over the world. Pathogenesis, clinical pictures, therapy, and prognosis are the same as for the phaeohyphomycoses.
Opportunistic yeast mycoses. Other yeasts besides the most frequent genus by far, Candida, are also capable of causing mycoses in immunosuppressed patients. They include Torulopsis glabrata, Trichosporon beigelii, and species of the genera Rhodotorula, Malassezia, Saccharomyces, Hansenula, and others. These “new” mycoses are not endogenous, but rather exogenous infections. In clinical and therapeutic terms, they are the same as candidiasis. Malassezia furfur occasionally causes catheter sepsis in premature neonates and persons who have to be fed lipids parenterally. Lipids encourage growth of this yeast.
Penicilliosis. This fungal infection is caused by the dimorphic fungus Penicillium marneffei, which probably inhabits the soil. P. marneffei infections are one of the most opportunistic infections most frequently seen in AIDS patients who either live in Southeast Asia or have stayed in that area for a while. The infection foci are located primarily in the lungs, from where dissemination to other organs can take place. The therapeutic of choice in the acute phase is amphotericin B, this treatment must be followed by long-term prophylactic azoles (itraconazole) to prevent remission.
Pneumocystis carinii (Pneumocystosis)
Pneumocystis carinii is a single-celled, eukaryotic microorganism that was originally classified as a protozoan, but is now considered a fungus. This pathogen can cause pneumonia in persons with defective cellular immune systems, in particular those showing AIDS. Extrapulmonary manifestations are also recorded in a small number of cases. Laboratory diagnostic methods include direct detection of the microbes under the microscope, by means of direct immunofluorescence or PCR. Appropriate anti-infective agents for therapy include cotrimoxazole, pentamidine, or a combination of the two.
Pneumocystis carinii is a single-celled, eukaryotic microorganism that was, until recently, classified with the protozoans. Molecular DNA analysis has revealed that it resembles fungi more than it does protozoans, although some of the characteristic properties of fungi, such as membrane ergosterol, are missing in Pneumocystis carinii. This microbe occurs in the lungs of many mammalian species including humans without causing disease in the carriers. Clinically manifest infections emerge in the presence of severe underlying defects in cellular immunity, as in AIDS.
Morphology and developmental cycle. Three developmental stages are known for P. carinii. The trophozoites are elliptical cells with a diameter of 1.5-5 µm. presumably, the trophic form reproduces by means of binary transverse fission, i.e., asexually. Sexual reproduction does not begin until two haploid trophozoites fuse to make one diploid sporozoite (or precyst), which are considered to be an intermediate stage in sexual reproduction. After further nuclear divisions, the sporozoites possess eight nuclei at the end of their development. The nuclei then compartmentalize to form eight spores with a diameter of 1-2 µm each, resulting in the third stage of development, the cyst. The cysts then release the spores, which in turn develop into trophozoites.
Culture. P. carinii cannot be grown in nutrient mediums. It can go through a maximum of 10 developmental cycles in cell cultures. Sufficient propagation is only possible in experimental animals, e.g., rats. This makes it difficult to study the pathogen's biology and the pathogenic process and explains why all aspects of these infections have not yet been clarified.
Pathogenesis and clinical pictures. Humans show considerable resistance to P. carinii infections, which explains why about two-thirds of the populace are either carriers or have a history of contact with the organism. Disease only becomes manifest in the presence of defects in the cellular immune system. Of primary concern among the clinical manifestations is the interstitial pneumonia. Profuse proliferation of the pathogen in the alveoli damages the alveolar epithelium. The pathogens then penetrate into the interstitium, where they cause the pneumonia. Starting from the primary infection foci, the fungi spread to other organs in 1-2% of cases, causing extrapulmonary P. carinii infections (of the middle ear, eye, CNS, liver, pancreas, etc.).
Diagnosis. Suitable types of diagnostic material include pulmonary biopsies or bronchoalveolar lavage (BAL) specimens from the affected lung segments. Grocott silver staining can be used to reveal cysts and Giemsa staining shows up trophozoites and sporozoites. Direct immunofluorescence, with labeled monoclonal antibodies to a surface antigen of the cysts, facilitates detection

(see Fig. 6.7c). Amplification of specific DNA sequences using the PCR has recently come to the fore as a useful molecular detection method.
Therapy. Acute pneumocystosis is treated with cotrimoxazole (oral or parenteral) or pentamidine (parenteral) or a combination of both of these anti-infective agents. Pentamidine can also be applied in aerosol form to reduce the side effects.
References
Kayser, F. H. (2005). Medical Microbiology. Thieme Stuttgart. New York.
الاكثر قراءة في الفطريات
اخر الاخبار
اخبار العتبة العباسية المقدسة